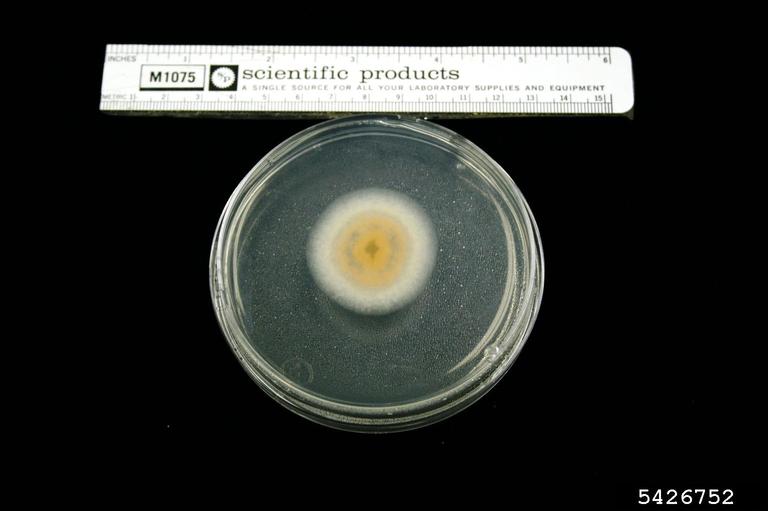

Image Number: 5426752
Photographer:
Organization:
Descriptor:
Culture
Description:
bottom view at 2 days at 25C
Image type:
Laboratory
You must attribute the work in the manner specified (but not in any way that suggests endorsement). You may not use this work for commercial purposes unless permission is granted by the photographer or copyright owner.
Image location:
Subject
| Kingdom: Fungi |
| Phylum: Ascomycota |
| Subphylum: Pezizomycotina |
| Class: Sordariomycetes |
| Subclass: Sordariomycetidae |
| Order: Incertae sedis |
| Family: Glomerellaceae |
| Genus: Colletotrichum |
| Subject: Colletotrichum spp. Corda |
Host
There is no applicable taxonomy of higher classification for this subject.
Node Affiliation:
Image uploaded:
Tuesday, August 17, 2010
Image last updated:
Tuesday, December 7, 2010